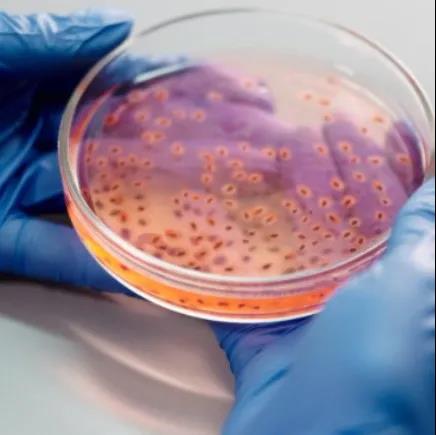

清洁、干燥的压缩空气是保持高效生产过程的关键。另一方面,微生物生长导致压缩空气供应中的污染会迅速破坏高效流程的一件事。正如您可能已经猜到的那样,压缩空气系统中的细菌和真菌等微生物非常危险,会危及应用的完整性并污染最终产品。这在医疗、制药、食品和饮料行业尤为重要,因为微生物的存在可能会带来灾难性的后果。让我们更多地了解微生物为何会存在于您的压缩空气供应中,以及如何减少/防止它们未来的生长。
为什么微生物会在压缩机装置中滋生?
空气压缩后变得非常温暖和潮湿,微生物在这些环境中茁壮成长!在合适的条件下,微生物(包括霉菌、酵母和细菌)会在您的压缩机系统中生长和繁殖,这会对您的空气质量和最终产品产生负面影响。如果你想抑制它们的生长,你能做的事情就是创造一个让它们难以生存的环境。
如何防止压缩机系统中微生物滋生?
仅仅了解微生物可以在压缩空气中生长是不够的;您需要制定计划,不仅要处理现有的微生物污染,还要减少/防止额外的生长。您可以采取以下四项措施来抑制其增长:
避免潮湿
空气干燥器和后冷却器是有助于保持压缩空气干燥的两件设备。干燥器用于去除压缩空气中的水分。根据应用的纯度要求,您可以使用冷冻式干燥机或除湿干燥机;除湿干燥机能够将空气干燥至超干燥水平,这可能更有效地防止微生物的生长。后冷却器以类似的方式运行,直接放置在压缩机后面,用于去除否则会在整个系统中传播的冷凝水。
过滤是关键
确保在整个压缩机安装过程中使用多个过滤器!确保空压机过滤器得到良好维护并定期更换它们很重要,因为这些可能是微生物生长的理想环境。
测试您的压缩空气
想确保您的压缩空气干净吗?定期检测是否存在微生物,包括细菌、霉菌和真菌。有多种测试可用,因此我们建议联系值得信赖的压缩空气专家,讨论哪种测试最适合您的设施。
处理压缩空气泄漏。所有压缩空气装置都有泄漏,这些不仅会在能源方面给您的业务造成巨大损失,而且还是污染物进入并开始在整个压缩机系统中循环的理想场所。修复泄漏不仅可以减少污染物进入的位置,还可以提高系统的能源效率。
压缩机环境
虽然并非总是可行,但请尝试将压缩机放置在凉爽干燥的地方。这将有助于抑制那些讨厌的微生物的生长!

